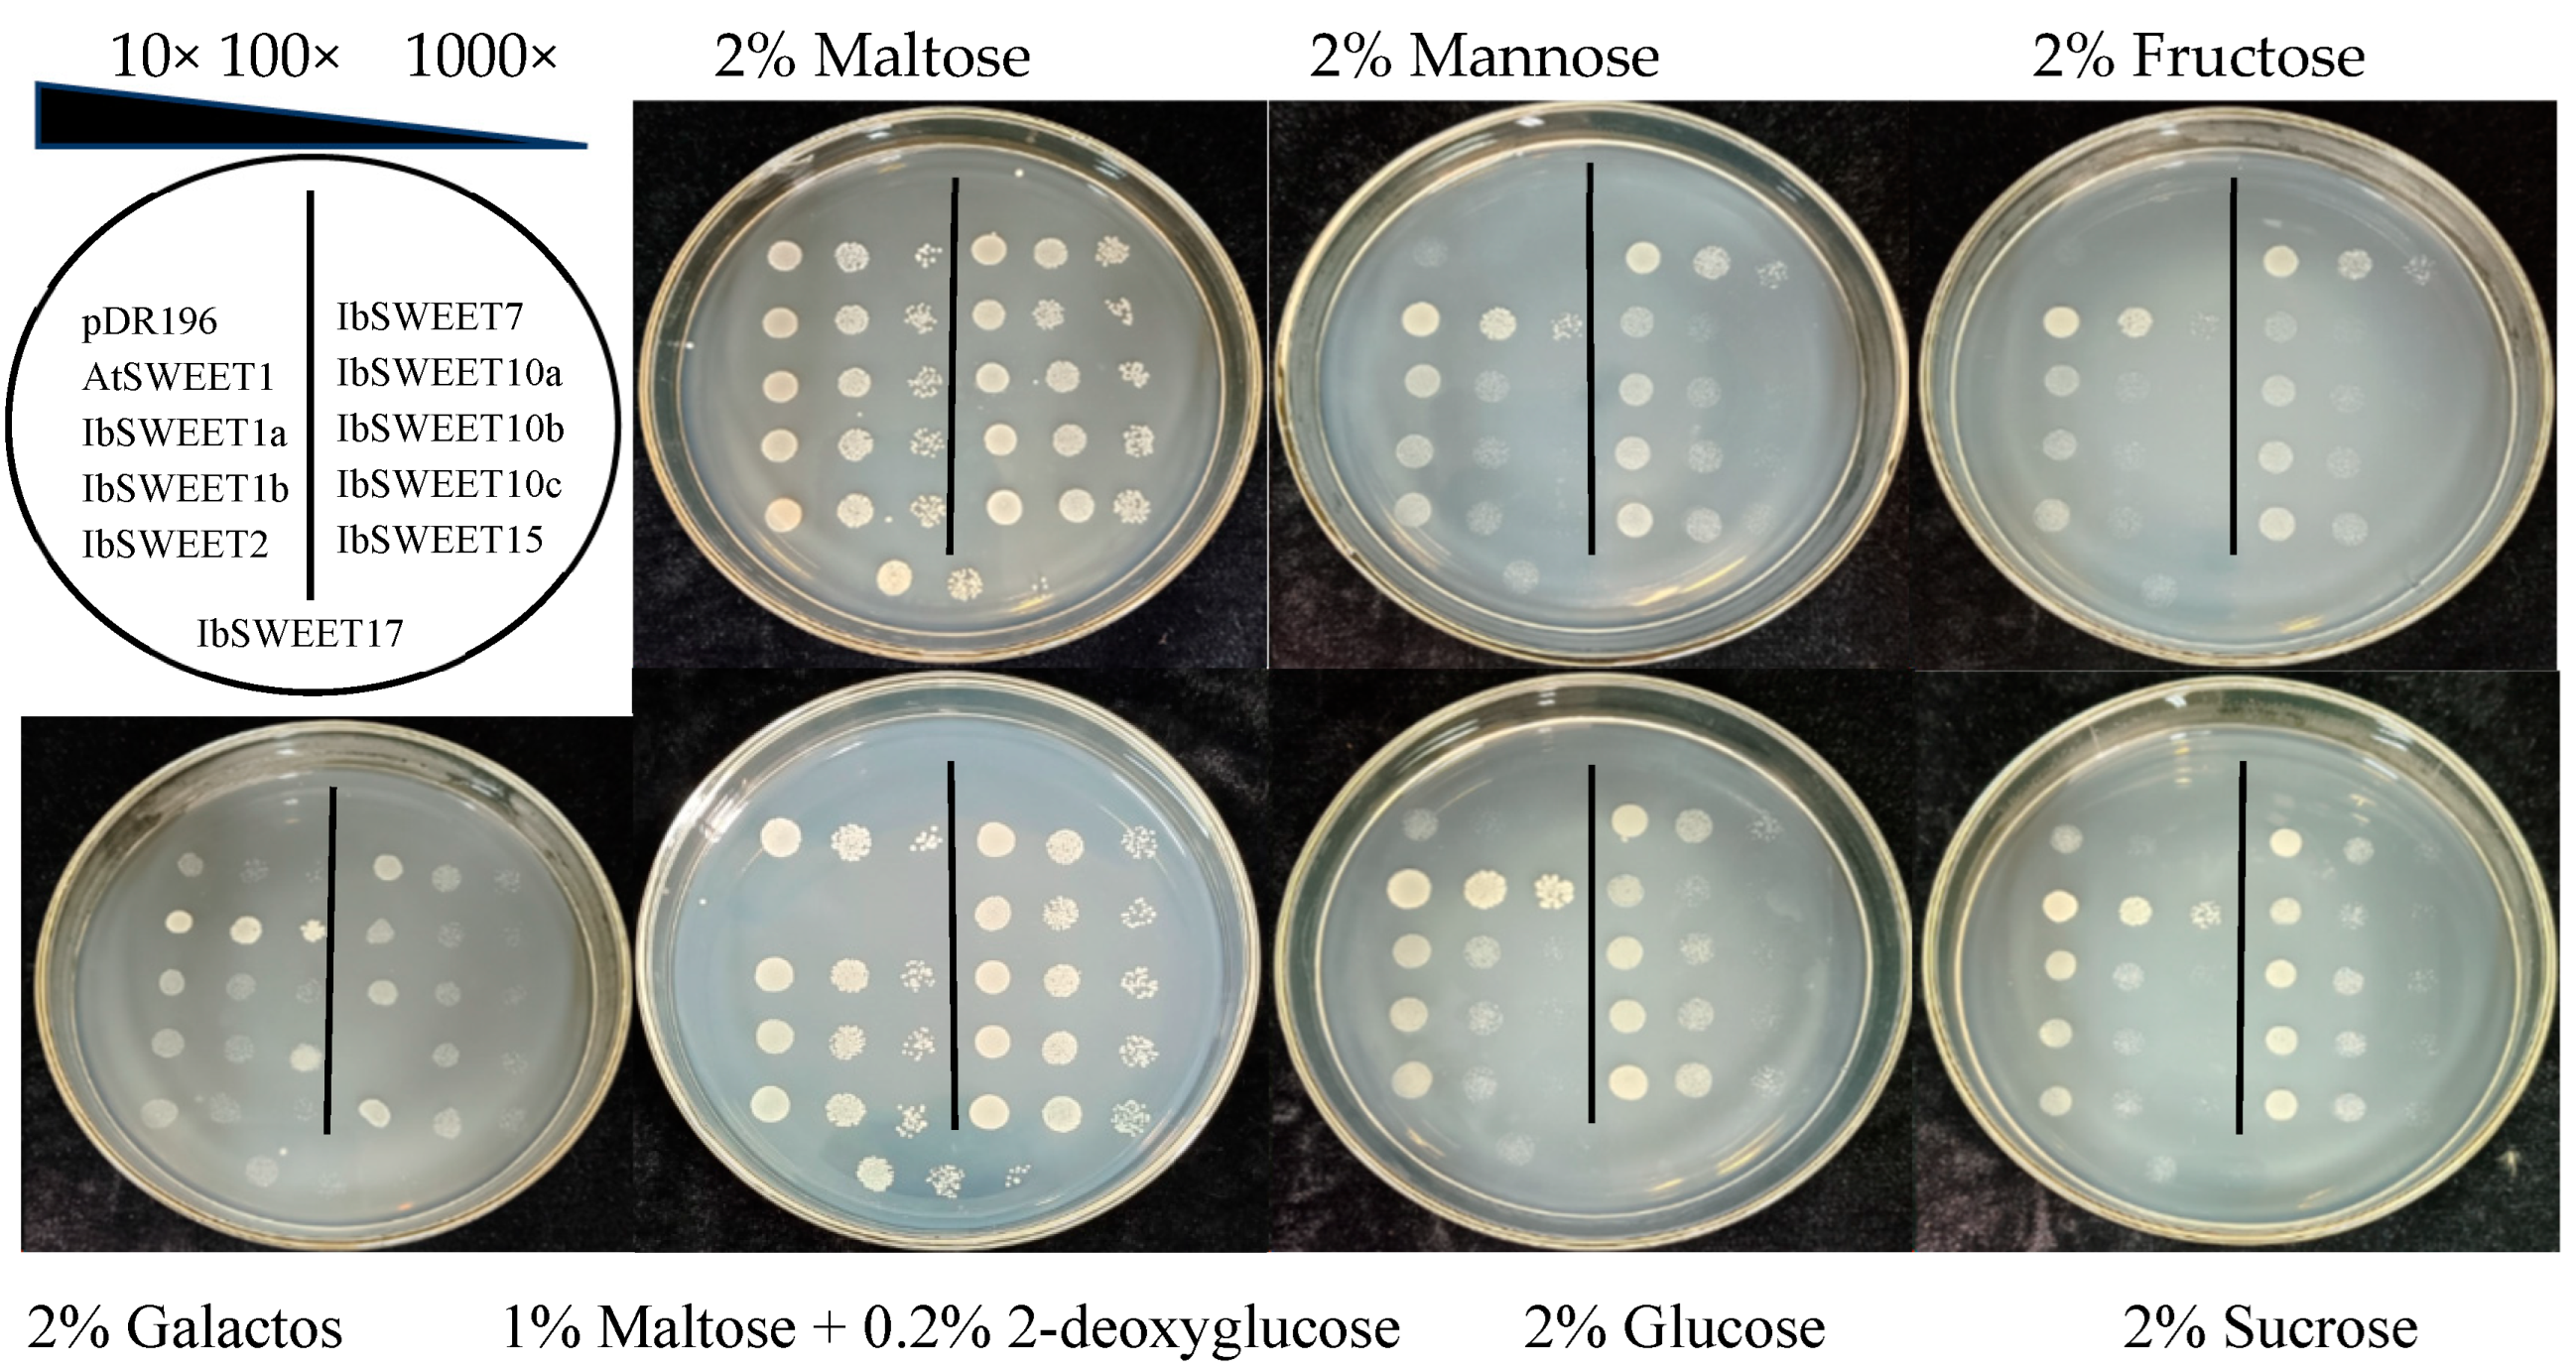
Ijms 24 16615 g008

Abstract
Sugar Will Eventually be Exported Transporter (SWEET) genes play an important regulatory role in plants’ growth and development, stress response, and sugar metabolism, but there are few reports on the role of SWEET proteins in sweet potato. In this study, nine IbSWEET genes were obtained via PCR amplification from the cDNA of sweet potato. Phylogenetic analysis showed that nine IbSWEETs separately belong to four clades (Clade I~IV) and contain two MtN3/saliva domains or PQ-loop superfamily and six~seven transmembrane domains. Protein interaction prediction showed that seven SWEETs interact with other proteins, and SWEETs interact with each other (SWEET1 and SWEET12; SWEET2 and SWEET17) to form heterodimers. qRT-PCR analysis showed that IbSWEETs were tissue-specific, and IbSWEET1b was highly expressed during root growth and development. In addition to high expression in leaves, IbSWEET15 was also highly expressed during root expansion, and IbSWEET7, 10a, 10b, and 12 showed higher expression in the leaves. The expression of SWEETs showed a significant positive/negative correlation with the content of soluble sugar and starch in storage roots. Under abiotic stress treatment, IbSWEET7 showed a strong response to PEG treatment, while IbSWEET10a, 10b, and 12 responded significantly to 4 °C treatment and, also, at 1 h after ABA, to NaCl treatment. A yeast mutant complementation assay showed that IbSWEET7 had fructose, mannose, and glucose transport activity; IbSWEET15 had glucose transport activity and weaker sucrose transport activity; and all nine IbSWEETs could transport 2-deoxyglucose. These results provide a basis for further elucidating the functions of SWEET genes and promoting molecular breeding in sweet potato.
1. Introduction
In plants, photosynthesis provides a material basis for plant growth and development, with up to 50–80% of photosynthates being transported from the phloem of the leaf to other organs to meet the needs of non-photosynthetic organs [1,2]. Sucrose is the main carbohydrate delivered by the source tissue to the sink tissue. Sugar transport is accomplished by sugar transporters, including monosaccharide transporters (MSTs) [3]; sucrose transporters (SUTs) [4,5]; and sugars-will-eventually-be-exported transporters (SWEETs) [6]. There are two different ways that sucrose enters the sink organ, the symplast pathway and the apoplast pathway [7,8]. The symplast pathway is accomplished via plasmodesmata, while the apoplast pathway occurs via two plasma-membrane-localized sugar transporters, SUTs and SWEETs [9]. In the apoplast pathway, sucrose is hydrolyzed into hexose (glucose and fructose), followed by hexose, using MSTs and SWEETs to complete source–sink transport [10].
SWEETs play important physiological roles in plants’ growth and development, stress response, and sugar metabolism [11]. AtSWEET11 and AtSWEET12 are important sucrose efflux transporters that co-operate to exert different physiological roles. Both transporters are involved in apoplast phloem loading, seed filling, and altered sugar levels at the site of pathogen infection [12,13]. Similarly, SvSWEET4a is a high-capacity glucose and sucrose transporter and is highly expressed in various maternal and offspring tissues within the seed, the vascular parenchyma of the peduncle and the xylem parenchyma of the stem, involved in the apoplast transport pathway of sink tissues [14]. SWEET4 homologue [15,16,17], SlSWEET12c [18], SlSWEET15 [19], CsSWEET7a [20], XsSWEET10 [21], and others have also been reported to be involved in phloem unloading and post-phloem sugar transport pathways in sink tissues and usually have high expression levels in sink tissues. NEC1 is a homologue of SWEET9 and was found to play a key role in nectar secretion [22,23], with AtSWEET13 and AtSWEET14 mainly working at the anther wall later in development. The loss of AtSWEET13 and AtSWEET14 leads to reduced pollen viability, thus reducing pollen germination, but SWEET9 completely rescued atsweet13, 14 pollen viability and germination defects; AtSWEET13 and AtSWEET14 may be responsible for sucrose efflux into the germ chamber, supporting pollen development to maturity [24]. In addition, SlSWEET5b [25], JsSWEET9, JsSWEET2 [26], etc., are also associated with flower development. The plasma-membrane-localized MtN3 protein SAG29 (AtSWEET15) was mainly expressed in senescent tissues and was induced by osmotic stress through an abscisic-acid-dependent pathway and accelerated plant senescence [27]. Similarly, the overexpression of OsSWEET5 and PbSWEET4 led to accelerating senescence in rice and strawberry leaves, respectively, probably due to enhancing sugar export from the leaves [28,29]. SWEETs are also associated with plant grain filling and fruit enlargement [18,19,20,30,31], abiotic stress [32,33,34,35,36,37,38], and biological stress [39,40,41,42,43] in plants.
Sweet potato is the seventh largest food crop in the world [44] and is an important cash crop. Its roots are rich in starch and soluble sugar, which can be used as food, feed, and industrial raw materials. Sweet potato is a highly heterozygous hexaploid plant, so the genetic study of sweet potato is very complicated. The development of genetics and genomics has enabled sweet potato and crop improvement to facilitate and accelerate the genetic improvement of this important rhizome crop through breeding, combining state-of-the-art multi-genomics such as genomic selection and gene editing. Agrobacterium-tumefaciens-mediated transformation of sweet potato provides the possibility of genome-modified breeding (including transgenic and genome editing breeding) [45]. Twenty-seven IbSWEETs were identified in sweet potato, which play multiple important roles in plant growth, storage root development, carotenoid accumulation, hormone crosstalk, and the abiotic stress response [46]. In addition, IbSWEET10 could enhance the resistance of sweet potato to Fusarium oxysporum [47]; IbSWEET15 increased the content of soluble sugars and starch in Arabidopsis seeds, while significantly reducing the soluble sugar content in leaves [48]. Considering the important role of SWEETs in plant development and to gain a more comprehensive and deeper understanding of the role of SWEET genes in the growth, development, and sugar accumulation of sweet potato, we conducted further research. In this study, nine SWEETs were screened for up/downregulation using RNA-seq datasets (submitted to NCBI with the accession number PRJNA678375), and we obtained the SWEET gene sequences from the sweet potato database (http://public-genomes-ngs.molgen.mpg.de/sweetpotato/ (accessed on 14 November 2023)). Nine IbSWEETs were obtained based on PCR amplification technology, and we performed gene characterization, protein structure, and transmembrane structure analysis. The qRT-PCR analysis indicated that they are tissue-specific and respond to abiotic stress. Heterologous expression in yeast revealed the substrates that transported by IbSWEET proteins. This study further clarified the function of IbSWEETs and promotes the molecular breeding of sweet potato.
2. Results
2.1. Molecular Cloning and Protein Characterization of IbSWEETs
To better understand the role of IbSWEETs in the growth and development process of sweet potato, we designed primers based on the SWEETs sequence obtained from the sweet potato genome and generated nine IbSWEET genes by PCR amplification from the cDNA of sweet potato (Supplemental Figure S1). These IbSWEET genes were named IbSWEET1a, 1b, 2, 7, 10a, 10b, 12, 15, and 17 according to the Arabidopsis homologous genes. The phylogenetic tree analysis indicated that nine IbSWEETs belong to four distinct clades (Clade I~IV) (Figure 1). These nine IbSWEET genes encode 234 to 305 amino acids; the theoretical isoelectric points (pI) ranged from 5.46 to 9.51; the molecular weight (MW) was between 25.61 to 34.36 (kD); the instability index (II) was between 24.29 and 51.82 and, among them, four IbSWEETs (IbSWEET1b, 7, 15, and 17) were less than 40, which were stable proteins, and the others were unstable proteins; the aliphatic index was 114.63–126.97; and all the hydrophobic indexes were greater than 0, so all IbSWEETs were hydrophobic proteins (Table 1). Subcellular localization prediction showed that IbSWEET1a and IbSWEET1b were localized on the plasma membrane, IbSWEET17 was localized on the vacuole membrane, and others were localized on chloroplasts (Table 1).
Figure 1.
Phylogenetic relationships of 9 IbSWEETs and 17 AtSWEETs, 21 OsSWEETs, and 15 VvSWEETs. The neighbor-joining tree was generated using MEGA X with 1000 bootstrap replicates. SWEET gene family are distinguished by different colors. The yellow square marks are sweet potato SWEETs.
Table 1.
The protein characterization of 9 IbSWEETs in sweet potato.
Conserved domain analysis showed that IbSWEETs contain two MtN3/saliva domains (CDD accession No. pfam03083) or PQ-loop superfamily (CDD accession No. cl21610) (Table 1), IbSWEET17 contained six transmembrane structures, the other eight IbSWEETs contained seven transmembrane domains (Figure 2), and the protein tertiary structure of IbSWEETs also clearly demonstrated the various transmembrane domains (Figure 3).
Figure 2.
The transmembrane domains of IbSWEET proteins. The position of N- and C-terminal domains of the protein are indicated by pink or blue lines. Table on the right bottom shows the location of each protein in this figure.

Figure 3.
Structural modeling of IbSWEETs protein. Gray dots indicate the phospholipid bilayer. Table on the right bottom shows the location of each protein in this figure.
2.2. Protein Interaction Network of IbSWEETs
To explore the potential regulatory network of IbSWEETs, we constructed a SWEET interaction network based on Arabidopsis homologous proteins (Figure 4). Protein interaction prediction showed that seven SWEETs could interact with other proteins and SWEETs (SWEET1 and SWEET12; SWEET2 and SWEET17) could also interact with each other to form heterodimers. Except for SWEET7 and SWEET15, the other five SWEETs all interact with the sugar transporter protein (STP) or sucrose transporter (SUC). In addition, SWEET2 could interact with 26s proteasome subunit RPT1B; SWEET7 could interact with EPFL1, PILS (pins-likes), and transcription factors TCX7 and TCX8; and SWEET15 could interact with proteins related to plant senescence regulation SAG12/13, non-yellow coloring1 (NYC 1), transcription factors BHLH13/14, and NAC92. These results suggest that SWEETs are involved in the regulation of growth and development in sweet potato.
Figure 4.
Functional interaction networks of IbSWEETs in sweet potato according to orthologues in Arabidopsis. Network nodes represent proteins and lines indicate protein–protein associations. The size of the nodes indicate the number of interacting proteins. Orange circles represent SWEET proteins and green circles represent other proteins; the dashed orange line represents the formation of heterodimers between two SWEETs.
2.3. Sugar, Starch Level, and Weight of Sweet Potato Storage Roots
In order to understand the sugar, starch content, and individual weight changes of sweet potato storage roots, we determined the sugar and starch level and the individual weight of sweet potato storage roots at different periods (60, 90, and 120 days (d) after transplanting). As shown in Figure 5, the soluble sugar and starch content and the individual weight of single storage roots of sweet potato cultivars “xiguahong” (XGH) and “guijingshu 8” (GJ8) increased with the growth of storage roots. The soluble sugar content in XGH was higher than in GJ8 (Figure 5A) but the starch content was just the opposite (Figure 5B). The glucose and fructose content of XGH increased first and then decreased, while the glucose and fructose content of GJ8 did not change significantly and the content was lower than XGH in each period (Figure 5C). The sucrose content of both XGH and GJ8 continued to rise, and it was lower in GJ8 than XGH (Figure 5C). The individual weight of sweet potato storage roots was heavier in XGH than GJ8 at each period (Figure 5D).
Figure 5.
Sugar, starch content, and weight of storage root changes in two sweet potato cultivars in different periods. (A): soluble sugar content. (B): starch content. (C): glucose, fructose, and sucrose content. (D): individual storage root weight. Letters ‘a–c’ indicate different changes in different development periods of the same cultivar (p < 0.05), according to Duncan’s multiple range test using SPSS software (Version: 26).
2.4. Expression Patterns of IbSWEETs in Different Tissues and Developmental Periods
To understand the potential biological function of IbSWEETs in the growth and development of sweet potato, we analyzed the expression levels of nine IbSWEETs in the roots, stems, and leaves of two sweet potato cultivars (GJ8 and XGH) via real-time quantitative PCR (qRT-PCR) (Figure 6). Fibrous roots at 15 d after transplanting were used as a control to calculate the relative expression levels of roots, stems, and leaves at 30, 60, 90, and 120 d after transplanting. The results showed that the relative expression levels of IbSWEET1a and IbSWEET17 were lower in roots, stems, and leaves (Figure 6) and the relative expression level of IbSWEET2 was lower in roots and stems, while higher expression levels were detected in leaves, with about five times higher expression than in fibrous roots (Figure 6E,F); IbSWEET1b was mainly expressed in sweet potato roots and stably upregulated with the growth and development of the roots (Figure 6A,B); IbSWEET15 was expressed at a low level in stems and was highly expressed by more than 15 times (Figure 6A,B) in the root expansion period (30~90 d after transplanting) and had the highest expression in leaves, up to 100 times (Figure 6E,F); IbSWEET7, 10a, 10b, and 12 were highly expressed in sweet potato leaves and more than 100 times that of roots and stems (Figure 6E,F). Nine IbSWEET genes shared the same expression trends in two sweet potato cultivars. These results suggest that IbSWEETs may play different roles in different developmental periods and various tissues of sweet potato.
Figure 6.
IbSWEETs expression analysis of different sites at two sweet potato cultivars in different periods. Note: the left side is the expression analysis in the root (A), stem (C), and leaf (E) of GJ8, respectively. The right side is the expression analysis in the root (B), stem (D), and leaf (F) of XGH, respectively. FR: fibrous root. Letters ‘a–d’ indicate different changes in different development periods of the same SWEET gene (p < 0.05), according to Duncan’s multiple range test using SPSS software (Version: 26).
To investigate the correlation between the sugar and starch content, individual root weight, and the expression of IbSWEETs, we analyzed the data using the bivariate Spearman of SPSS software (Version: 26). The results showed that the expression of IbSWEET1b was positively correlated with the soluble sugar, starch, sucrose content, and individual storage root weight; IbSWEET15 expression was positively correlated with fructose content in XGH and GJ8. In addition, in XGH, the expression of IbSWEET10b was negatively correlated with the soluble sugar, starch, sucrose content, and individual storage root weight; the expression of IbSWEET1a, 7, 10a, and 12 was negatively correlated with glucose content, while IbSWEET17 was opposite; the expression of IbSWEET2 and IbSWEET15 was positively correlated with fructose content (Table 2). In GJ8, the expression of IbSWEET1b and IbSWEET7 was positively correlated with the soluble sugar, starch, sucrose content, and individual storage root weight and negatively correlated with fructose content, while the expression of IbSWEET12 and IbSWEET15 was negatively correlated with the above indexes but positively correlated with the fructose content. In addition, the expression of IbSWEET1a and IbSWEET10a was positively correlated with the glucose content (Table 3). These results indicate that the expression of IbSWEETs may be related to the sugar accumulation of sweet potato storage roots.
Table 2.
Correlation between expression of IbSWEETs and sugar, starch content, and storage root weight of XGH.
Table 3.
Correlation between expression of IbSWEETs and sugar, starch content, and storage root weight of GJ8.
2.5. Expression Patterns of IbSWEETs in Response to Abiotic Stress
To further understand the physiological function of IbSWEETs under different abiotic stresses, we analyzed the expression patterns in leaves of sweet potato cultivar GJ8 after 4 °C, 200 mM NaCl, 20% PEG6000, 100 μM ABA treatment. The results showed that seven IbSWEETs showed different expression patterns (IbSWEET1a and IbSWEET1b were not expressed in leaves or the expression was extremely low) (Figure 7). After PEG treatment, the relative expression of IbSWEET2, 7, and 15 decreased first and then increased compared to 0 h, IbSWEET2 and IbSWEET15 only increased near the expression level of treatment 0 h, while IbSWEET7 increased to about seven times the expression level at 0 h. The relative expression levels of IbSWEET10a, 10b, 12, and 17 decreased after a slight increase, and they all fell below the 0 h expression level (Figure 7A).

Figure 7.
Gene expression patterns of IbSWEETs in response to different abiotic stresses in GJ8 as determined by qRT-PCR. Note: (A) 20% PEG6000, (B) 4 °C, (C) 200 mM NaCl, (D) 100 μM ABA. Letters ‘a–d’ indicate different changes in different treatment periods of the same SWEET gene (p < 0.05), according to Duncan’s multiple range test using SPSS software (Version: 26).
After 4 °C treatment, the relative expression of IbSWEET2 did not change significantly with the extension of treatment time, that of IbSWEET7 was wavy, and the highest expression reached more than two times that of 0 h. The relative expression of IbSWEET10a, 12, and 17 increased first and then decreased but was consistently higher than 0 h; that of IbSWEET10b increased steadily with the treatment time, while the relative expression of IbSWEET15 decreased to around the expression level of 0 h (Figure 7B).
After NaCl treatment, IbSWEET10a, 10b, and 12 had the highest expression at 1 h, then continuously decreased, and was less than 0 h. The relative expressions of IbSWEET7 and IbSWEET15 decreased first and then increased at 24 and 48 h. The relative expression of IbSWEET17 was shown by a sustained rise and then a decrease below 0 h (Figure 7C).
After ABA treatment, the relative expression of IbSWEET2 ascended after being slightly decreased and was maintained at about twofold expression. IbSWEET10a, 10b, and 12 were all significantly induced at 1 h after treatment and then continued rising again after falling. The relative expression of IbSWEET7 and IbSWEET15 were lower than 0 h after ABA treatment, and that of IbSWEET17 rose first and then decreased (Figure 7D).
2.6. Complementation of Yeast EBY.VW4000
SWEET has been demonstrated to mediate the transport of different sugars. To determine whether IbSWEETs transport sugars, IbSWEETs were heterologously expressed in the yeast mutant EBY.VW4000, with pDR196 as a negative control and AtSWEET1 as a positive control. The EBY.VW4000 transformed with empty vectors and constructs could be grown on synthetic deficient (SD) media containing 2% maltose, indicating the presence of the expression vector or target gene (Figure 8).
Figure 8.
Complementation growth assay in the yeast EBY.VW4000 mutant.
Expression of IbSWEET7 effectively restored EBY.VW4000 growth on media supplemented with fructose, mannose, and glucose. Expression of IbSWEET15 restored EBY.VW4000 growth on media containing glucose, and all yeast cells could grow slowly on galactose media.
2-deoxyglucose with poor metabolic capacity was used as a sensitive tool to detect the transport of sugar analogues [49]. The EBY.VW4000 transformed with the empty vectors were grown on medium supplemented with 2-deoxyglucose. All yeast cells, except those transformed with AtSWEET1, resumed growth on 1% maltose + 0.2% 2-deoxyglucose medium, indicating that these nine IbSWEETs can transport glucose analogues. In addition, IbSWEET10a, 10b, 12, and 15 could grow slowly in the medium supplemented with sucrose. The above results suggested that these nine IbSWEETs may play a role in hexose and sucrose transport (Figure 8).
3. Discussion
3.1. SWEET Mediates the Transport of Different Sugars
In 2010, Chen et al. [6] identified a new class of sugar-will-eventually-be-exported transporter (SWEET) proteins transporting glucose and other oligosaccharides from Arabidopsis by the fluorescence resonance energy transfer sensing technology (FRET sensor). It acts independently of H+-ATPase to transport sugar across the membrane [50,51,52]. Then, SWEET genes have been identified from many plants, such as rice, tomato, barley, alfalfa, garlic, etc. [52,53,54,55,56].
AtSWEET1 has the ability to take up glucose in human embryonic kidney cells HEK293T and also has the same properties in yeast hexose absorption-deficient mutants (EBY.VW4000) and Xenopus oocytes [6,12]. The EBY.VW4000 mutant lacks the endogenous hexose transporters HXT1-HXT17 and GAL2 and grows normally on media containing maltose or slowly with galactose but not on media containing glucose, fructose, mannose, or sucrose [57]. AtSWEET8 is a glucose transport protein too and both AtSWEET8 and AtSWEET1 are abundantly expressed in Arabidopsis pollen tubes, suggesting that they may provide nutrients to the developing pollen tubes [6]. AtSWEET11 and AtSWEET12 mainly transport sucrose and, similarly, OsSWEET11 and OsSWEET14 are also transport carriers for low-affinity sucrose [12,13,58,59]. AtSWEET17 express in parenchyma cells and vascular tissues; it is a vacuolar fructose transporter, mainly responsible for fructose transport in roots and leaves [60]; AtSWEET16 also functions as a vacuolar sugar transporter responsible for glucose, fructose, and sucrose transport [61].
In this study, all nine IbSWEETs that heterologously expressed in yeast had glucose analogue transport activity but only two (IbSWEET7 and IbSWEET15) had glucose transport activity, while IbSWEET7 also had fructose and mannose transport activity. IbSWEET10a, 10b, 12, and 15 had weak sucrose transport activity and the other IbSWEETs did not detect sugar transport activity (Figure 8). In summary, different SWEET genes show differences in sugar transport activity.
3.2. SWEET Mediates Sugar Transport and Accumulation in Sweet Potato
The formation and development of sweet potato storage roots are crucial for root yield and quality. Storage root formation was thought to be a process of assimilate accumulation. Sucrose is the main product of photosynthesis, which is produced in mesophyll cells and then enters into the phloem cells for transport into various plant reservoir organs [62]. It has shown that SWEETs were involved in the transport and distribution of photosynthetic products in plants [12]. AtSWEET11 and AtSWEET12 localize on the plasma membrane of leaf phloem and are responsible for the transport of sucrose from parenchyma cells to the leaf exoplasm. The atsweet11, 12 double mutants exhibited slow-growing phenotype and reduced root sucrose content and increased leaf starch levels [12]. ZmSWEET15a had the highest expression in leaves and was highly correlated with leaf development and overexpression of ZmSWEET15a in maize reduced leaf sucrose content and increased grain sucrose content [63]. IbSWEET10a, 10b, 12, and 15 were highly expressed in leaves (Figure 6E,F) and had weak sucrose transport activity (Figure 8), so they may be involved in the export of sugar from sweet potato leaves.
In barley, reducing HvSWEET11b expression in developing grains reduced grain size, sink strength, endopolyploid endosperm cell number, and starch and protein content [64]. The highest expression of SlSWEET12c was observed in the red ripening stage of tomato fruit. Silencing of SlSWEET12c increased sucrose accumulation and reduced hexose quantity in tomato fruit; the opposite effect was observed with overexpression of SlSWEET12c [18]. Similarly, silencing of SlSWEET7a or SlSWEET14 increased the sugar content of the mature fruit, resulting in higher plants and larger fruit [31]. In watermelon, ClSWEET3 was involved in the storage of plasma membrane sugar transport in the vacuole of fruit cells. Knockdown of ClSWEET3 affected the sugar accumulation in the fruits [65]. In citrus, CitSWEET11d transcript was significantly correlated with sucrose accumulation, and sucrose levels of overexpressing CitSWEET11d in citrus calli and tomato fruits were higher than in wild type, indicating that CitSWEET11d promoted sucrose accumulation [66].
During the expansion of sweet potato storage roots, the content of sucrose and soluble sugar continued to increase (Figure 5) and the transcript of IbSWEET1b showed a significant positive correlation with the soluble sugar and sucrose of the storage roots (Table 2 and Table 3). Further comparison of IbSWEET1b expression in different tissues and at different developmental stages also suggested that IbSWEET1b was highly expressed in storage roots, indicating that it may play a role in sweet potato storage roots. IbSWEET15 also had high expression in the stage of storage root expansion and had glucose and sucrose transport activity, indicating that this gene plays a certain role in the swelling stage of sweet potato. In general, IbSWEET1b and IbSWEET15 may mediate the sugar transport and accumulation of the storage root of sweet potato.
3.3. SWEETs Participate in Regulating Abiotic Stress in Sweet Potato
Sucrose is the main product of photosynthesis and it is also penetrant, which prevents tissue damage under limited water availability. Thus, sucrose transport and distribution are key processes in plants in response to abiotic stresses [35]. Sugar concentrations increased significantly under biotic and abiotic stresses, such as cold, drought, and pathogen challenge [67,68]. The SWEET genes were reported to respond to various abiotic stresses. Under drought stress, AtSWEET4, 11, 12, 13, 14, and 15, OsSWEET12, 15, and 16 were induced [33,69]; after treatment with polyethylene glycol (PEG), AtSWEET2, 11, 13, and 15 were downregulated and sucrose transport between leaves and roots were decreased [7]. JcSWEET16 responded to drought and salt stress in leaves and the overexpression of JcSWEET16 in Arabidopsis altered the flowering time and salt tolerance levels without affecting the drought tolerance [70]. AtSWEET17 was a fructose-specific sugar transporter localized in the vacuolar membrane and the knockout mutant lines of AtSWEET17 exhibited reductive LR growth and reduced expression of LR development-associated transcription factors under drought stress, resulting in impaired drought tolerance in atsweet17 mutant lines [37].
In tea plants, CsSWEET genes played an important role in response to abiotic stress. CsSWEET16 contributed to sugar compartmentalization in the vacuole and to modifying cold tolerance in Arabidopsis [71]. Overexpression of MdSWEET16 in apple calli reduced its sucrose content but increased its cold tolerance [72] and transgenic plants overexpressing AtSWEET4 showed high freezing tolerance too [73]. Similarly, HfSWEET17 was overexpressed in tobacco and transgenic plants showed significantly more cold resistance than wild-type tobacco [34].
ZmSWEET1b was a typical sugar transporter, and the ZmSWEET1b knockout lines had significantly reduced sucrose and fructose content. After salt treatment, the ZmSWEET1b edited lines became more withered [74], while overexpression of DsSWEET17 improved salt tolerance in Arabidopsis [75]. The ABA-responsive transcription factor OsbZIP72 binded to the promoter, inducing high expression of OsSWEET13 and OsSWEET15 and regulating the transport and distribution of sucrose under abiotic stress, and this mechanism may be targeted for maintaining rice sugar homeostasis under drought and salt stress [35].
Moreover, some genes confer multiple stress tolerance to plants; for example, DsSWEET17 transgenic Arabidopsis had high tolerance to salt, osmotic, and oxidative stresses [76]. In our study, the SWEET genes had differential responses under various abiotic stresses. Under PEG treatment, IbSWEET2 and IbSWEET7 were upregulated and IbSWEET10a, 10b, 12, and 15 were downregulated. Under 4 °C treatment, IbSWEET10a, 10b, 12, and 17 were induced and the expression was upregulated. After NaCl treatment, IbSWEET10a, 10b, and 12 were strongly induced at 1 h after treatment, and IbSWEET2,10a, 10b, 12, and 17 were also induced after ABA treatment (Figure 8), suggesting that IbSWEETs may regulate the response of sweet potato to abiotic stress by regulating sugar transport and distribution.
4. Materials and Methods
4.1. Plant Materials and Growth Conditions
The sweet potato (Ipomoea batatas (L.) Lam) cultivars “xiguahong” (XGH) and “guijingshu 8” (GJ8) were used in this experiment. In early September, 30cm long stem tips were planted in the farm of Guangxi University (108°22′ E, 22°48′ N). Fibrous roots were collected at 15 days after transplanting; mature leaves (+2–+3 leaves) and corresponding stems and roots were collected at 30, 60, 90, and 120 days, respectively. The GJ8 25cm long stem tips growing consistently at 60 days (vigorous growth period) after cutting were taken and cultured in Hoagland nutrient solution until the roots grew to about 10 cm, processing them with 200 mM NaCl, 20% PEG6000, 100 μM ABA, and low temperature (4 °C). The third expanded leaves were collected at 0, 1, 6, 12, 24, and 48 h after NaCl, PEG, and ABA treatments and at 0, 1, 3, 6, and 12 h after 4 °C treatment, with three biological replicates. Samples were frozen immediately in liquid nitrogen and kept at −80 °C until analysis.
A part of storage roots harvested at 60, 90, and 120 days after transplanting were sliced then put into the oven at 105 °C and, after 30 min, the temperature was set to 70 °C and held until the samples were dried. Samples were crushed and screened for determining the soluble sugar content and starch content.
4.2. Gene Sequence and Phylogenetic Analysis
The molecular weight (MW), protein isoelectric point (pI), instability index, aliphatic index and hydrophilicity (GRAVY) of the IbSWEETs were analyzed by ExPASy (https://web.expasy.org/protparam/ (accessed on 13 November 2023)) [77]. Subcellular localization and protein tertiary structure prediction were analyzed via WoLF PSORT (https://www.genscript.com/wolf-psort.html (accessed on 13 November 2023)) and SWISS-MODEL (https://swissmodel.expasy.org/ (accessed on 13 November 2023)) [78].
The SWEET proteins from sweet potato and Arabidopsis thaliana, rice, and grape were used to establish the phylogenetic tree by MEGA X [79] with the neighbor-joining (NJ) method using the default settings, and the results were displayed with iTOL (http://itol.embl.de/ (accessed on 13 November 2023)).
4.3. SWEET Protein Interaction Network Prediction
Based on Arabidopsis homologue proteins, the SWEET protein interaction network was predicted using STRING (Version: 12.0, https://cn.string-db.org/ (accessed on 13 November 2023)) [80] and the protein interaction network was drawn using Cytoscape software (Version: 3.9.1) [81].
4.4. RNA Extraction and qRT-PCR
Total RNA was extracted using a plant RNA fast pickup kit (single column type) (Magen, code R4014-02, Guangzhou City, China) and the first strand cDNA synthesis was performed using TaKaRa PrimeScript RT reagent Kit with gDNA Eraser (Perfect Real Time) (TaKaRa, code RR047, Kyoto, Japan). The experimental operation was performed according to the kit instructions. The RNA concentration was obtained by measuring the absorption value of OD260 by ultramicrospectrophotometer (Themo Scientific NANO DROP ONE, Waltham, MA, USA). In a 20 μL reaction system, the first strand of cDNA was synthesized using 1000 ng RNA as a template. All qRT-PCR was performed in BIO-RAD CFX96 real-time system. The expression level was calculated using the 2−ΔΔCT method with IbACTIN gene as an internal reference.
4.5. Determination of Sugar and Starch
Soluble sugar and starch content were determined with the method described by Gao et al. [82]. Glucose, fructose, and sucrose were determined by ion chromatography. Chromatographic conditions: Dionex CarboPac PA1 Anion-exchange column, including analytical column (2 × 250 mm) and protective column (2 × 250 mm); column temperature was 35 °C. Mobile phase A was ultrapure water, B was NaOH aqueous solution (200 mmol), A: B was 91%: 9%, flow rate was 1 mL/min, and sample intake was 25 μL.
4.6. Functional Characterization of IbSWEETs by Heterologous Expression in Yeast
To test the biochemical properties of IbSWEETs, we constructed plasmids with an IbSWEETs-coding sequence domain in the yeast expression vector pDR196. The recombinant plasmids were obtained by inserting the coding sequences of IbSWEETs and AtSWEET1 (positive control) between pDR196 salI and the xhoI restriction site (Supplemental Figure S2).
The recombinant plasmid and pDR196 transformed hexose uptake-deficient yeast EBY.VW4000; the transformants were grown in synthetic deficient (SD) medium containing 2% (w/v) maltose as the sole carbon source and shaken to OD600 0.6 at 30 °C, 180 rpm. The bacterial solution was diluted to 10 times, 100 times, and 1000 times, and 10 μL diluted droplets were placed in SD/-uracil solid medium with 2% (w/v) maltose, glucose, sucrose, mannose, galactose, fructose, and 1% maltose + 0.2% 2-deoxyglucose as the sole carbon source, respectively. Yeast cells were grown for 3 to 5 days at 30 °C. Cell growth on different media were observed to study in which sugars that IbSWEETs proteins were involved.
5. Conclusions
In this study, nine IbSWEET genes were obtained, all with 2 MtN3 domains or PQ-loop superfamily and six to seven transmembrane domains and belonging to four different clades. Protein interaction prediction showed that SWEETs interact with monosaccharide transporters, sucrose transporters, and some transcription factors. qRT-PCR analysis demonstrated obvious tissue specificity of IbSWEETs and large differences in response to abiotic stresses. The expression level of some IbSWEETs showed a significant positive/negative relationship with the sugar and starch content and the weight of sweet potato storage roots. Yeast heterologous expression suggested that IbSWEETs transported different classes of sugars. The nine SWEET genes have different lengths, physicochemical properties, and large differences in protein tertiary structure. These differences may lead to their different sugar transport activities, so their response to abiotic stress was different and the correlation of sugar and starch accumulation between sweet potatoes was also different. The results provide a basis for further clarifying the function of SWEET genes in the growth and development of sweet potato.
Supplementary Materials
The following supporting information can be downloaded at: https://www.mdpi.com/article/10.3390/ijms242316615/s1.
Author Contributions
Data curation, J.H., X.F. and W.L.; formal analysis, J.H., X.F., W.L., Z.N. and Y.Z.; investigation, P.Z. and A.W.; methodology, J.H., D.X., J.Z. and L.H.; supervision, A.W., D.X., J.Z. and L.H.; validation, P.Z.; writing—original draft, J.H.; writing—review and editing, L.H. All authors have read and agreed to the published version of the manuscript.
Funding
This work was supported by the National Natural Science Foundation of China (32060419) and the Guangxi Innovation Team Project of Tubers of Modern Agricultural Industrial Technology System of China (nycytxgxcxtd-11).
Institutional Review Board Statement
Not applicable.
Informed Consent Statement
Not applicable.
Data Availability Statement
The data generated and analyzed during the present study are available on request from the corresponding author.
Acknowledgments
We thank wolf B. frommer of the Carnegie Institution, Stanford University, USA for the generous gift of EBY.VW4000 yeast strains and Shuzhen Zhang of Hainan University for sending the yeast strains to us.
Conflicts of Interest
The authors declare no conflict of interest.
Abbreviations
SWEET: Sugar will eventually be exported transporters; MtN3, Medicago truncatula nodulin 3; qRT-PCR, Quantitative Real-time Polymerase Chain Reaction; MST, monosaccharide transporter; SUT, sucrose transporter; SUC, sucrose carriers; STP, sugar transport protein; NEC1, Necrostatin 1; SAG29, senescence-associated gene 29; RNAi, RNA interference; PEG, Poly (ethylene glycol); ABA, abscisic acid; MW, molecular weight; kD, kilodalton; pI, protein isoelectric point; GRAVY, Grand average of hydropathicity; NYC1, non-yellow coloring1; SD, synthetic deficient; PILS, pins-likes; GA, gibberellin; HXT1 -HXT17, hexose transporter 1-hexose transporter 17; BHLH13/14, basic helix-loop-helix; TCX7/8, T-cell Xtend 7/8. LR, lateral roots.
References
- Ainsworth, E.A.; Bush, D.R. Carbohydrate Export from the Leaf: A Highly Regulated Process and Target to Enhance Photosynthesis and Productivity. Plant Physiol. 2011, 155, 64–69. [Google Scholar] [CrossRef]
- Kalt-Torres, W.; Kerr, P.S.; Usuda, H.; Huber, S.C. Diurnal Changes in Maize Leaf Photosynthesis. Plant Physiol. 1987, 83, 283–288. [Google Scholar] [CrossRef]
- Yamada, K.; Yamaguchi, K.; Shirakawa, T.; Nakagami, H.; Mine, A.; Ishikawa, K.; Fujiwara, M.; Narusaka, M.; Narusaka, Y.; Ichimura, K.; et al. The Arabidopsis CERK 1-associated kinase PBL 27 connects chitin perception to MAPK activation. EMBO J. 2016, 35, 2468–2483. [Google Scholar] [CrossRef]
- Riesmeier, J.W.; Willmitzer, L.; Frommer, W.B. Evidence for an essential role of the sucrose transporter in phloem loading and assimilate partitioning. EMBO J. 1994, 13, 1–7. [Google Scholar] [CrossRef] [PubMed]
- Riesmeier, J.W.; Willmitzer, L.; Frommer, W.B. Isolation and characterization of a sucrose carrier cDNA from spinach by functional expression in yeast. EMBO J. 1992, 11, 4705–4713. [Google Scholar] [CrossRef] [PubMed]
- Chen, L.-Q.; Hou, B.-H.; Lalonde, S.; Takanaga, H.; Hartung, M.L.; Qu, X.-Q.; Guo, W.-J.; Kim, J.-G.; Underwood, W.; Chaudhuri, B.; et al. Sugar transporters for intercellular exchange and nutrition of pathogens. Nature 2010, 468, 527–532. [Google Scholar] [CrossRef] [PubMed]
- Durand, M.; Mainson, D.; Porcheron, B.; Maurousset, L.; Lemoine, R.; Pourtau, N. Carbon source–sink relationship in Arabidopsis thaliana: The role of sucrose transporters. Planta 2018, 247, 587–611. [Google Scholar] [CrossRef]
- Sauer, N. Molecular physiology of higher plant sucrose transporters. FEBS Lett. 2007, 581, 2309–2317. [Google Scholar] [CrossRef]
- Williams, L.E.; Lemoine, R.; Sauer, N. Sugar transporters in higher plants—A diversity of roles and complex regulation. Trends Plant Sci. 2000, 5, 283–290. [Google Scholar] [CrossRef]
- Walker, J.C.; Hooker, W.J. Plant nutrition in relation to disease development: II. Cabbage clubroot. Am. J. Bot. 1945, 32, 487–490. [Google Scholar] [CrossRef]
- Jeena, G.S.; Kumar, S.; Shukla, R.K. Structure, evolution and diverse physiological roles of SWEET sugar transporters in plants. Plant Mol. Biol. 2019, 100, 351–365. [Google Scholar] [CrossRef]
- Chen, L.-Q.; Qu, X.-Q.; Hou, B.-H.; Sosso, D.; Osorio, S.; Fernie, A.R.; Frommer, W.B. Sucrose Efflux Mediated by SWEET Proteins as a Key Step for Phloem Transport. Science 2012, 335, 207–211. [Google Scholar] [CrossRef] [PubMed]
- Fatima, U.; Balasubramaniam, D.; Khan, W.A.; Kandpal, M.; Vadassery, J.; Arockiasamy, A.; Senthil-Kumar, M. AtSWEET11 and AtSWEET12 transporters function in tandem to modulate sugar flux in plants. Plant Direct 2023, 7, e481. [Google Scholar] [CrossRef] [PubMed]
- Chen, L.; Ganguly, D.R.; Shafik, S.H.; Danila, F.; Grof, C.P.L.; Sharwood, R.E.; Furbank, R.T. The role of SWEET4 proteins in the post-phloem sugar transport pathway of Setaria viridis sink tissues. J. Exp. Bot. 2023, 74, 2968–2986. [Google Scholar] [CrossRef] [PubMed]
- Hu, W.; Hua, X.; Zhang, Q.; Wang, J.; Shen, Q.; Zhang, X.; Wang, K.; Yu, Q.; Lin, Y.-R.; Ming, R.; et al. New insights into the evolution and functional divergence of the SWEET family in Saccharum based on comparative genomics. BMC Plant Biol. 2018, 18, 270. [Google Scholar] [CrossRef]
- Martin, A.P.; Palmer, W.M.; Brown, C.; Abel, C.; Lunn, J.E.; Furbank, R.T.; Grof, C.P.L. A developing Setaria viridis internode: An experimental system for the study of biomass generation in a C4 model species. Biotechnol. Biofuels 2016, 9, 45. [Google Scholar] [CrossRef] [PubMed]
- Sosso, D.; Luo, D.; Li, Q.-B.; Sasse, J.; Yang, J.; Gendrot, G.; Suzuki, M.; Koch, K.E.; McCarty, D.R.; Chourey, P.S.; et al. Seed filling in domesticated maize and rice depends on SWEET-mediated hexose transport. Nat. Genet. 2015, 47, 1489–1493. [Google Scholar] [CrossRef]
- Sun, J.; Feng, C.; Liu, X.; Jiang, J. The SlSWEET12c Sugar Transporter Promotes Sucrose Unloading and Metabolism in Ripening Tomato Fruits. Horticulturae 2022, 8, 935. [Google Scholar] [CrossRef]
- Ko, H.-Y.; Ho, L.-H.; Neuhaus, H.E.; Guo, W.-J. Transporter SlSWEET15 unloads sucrose from phloem and seed coat for fruit and seed development in tomato. Plant Physiol. 2021, 187, 2230–2245. [Google Scholar] [CrossRef]
- Li, Y.; Liu, H.; Yao, X.; Wang, J.; Feng, S.; Sun, L.; Ma, S.; Xu, K.; Chen, L.-Q.; Sui, X. Hexose transporter CsSWEET7a in cucumber mediates phloem unloading in companion cells for fruit development. Plant Physiol. 2021, 186, 640–654. [Google Scholar] [CrossRef]
- Guo, Y.; Song, H.; Zhao, Y.; Qin, X.; Cao, Y.; Zhang, L. Switch from symplasmic to aspoplasmic phloem unloading in Xanthoceras sorbifolia fruit and sucrose influx XsSWEET10 as a key candidate for Sugar transport. Plant Sci. 2021, 313, 111089. [Google Scholar] [CrossRef] [PubMed]
- Lin, I.W.; Sosso, D.; Chen, L.-Q.; Gase, K.; Kim, S.-G.; Kessler, D.; Klinkenberg, P.M.; Gorder, M.K.; Hou, B.-H.; Qu, X.-Q.; et al. Nectar secretion requires sucrose phosphate synthases and the sugar transporter SWEET9. Nature 2014, 508, 546–549. [Google Scholar] [CrossRef] [PubMed]
- Iftikhar, J.; Lyu, M.; Liu, Z.; Mehmood, N.; Munir, N.; Ahmed, M.A.A.; Batool, W.; Aslam, M.M.; Yuan, Y.; Wu, B. Sugar and Hormone Dynamics and the Expression Profiles of SUT/SUC and SWEET Sugar Transporters during Flower Development in Petunia axillaris. Plants 2020, 9, 1770. [Google Scholar] [CrossRef] [PubMed]
- Wang, J.; Xue, X.; Zeng, H.; Li, J.; Chen, L. Sucrose rather than GA transported by AtSWEET13 and AtSWEET14 supports pollen fitness at late anther development stages. New Phytol. 2022, 236, 525–537. [Google Scholar] [CrossRef]
- Ko, H.-Y.; Tseng, H.-W.; Ho, L.-H.; Wang, L.; Chang, T.-F.; Lin, A.; Ruan, Y.-L.; Neuhaus, H.E.; Guo, W.-J. Hexose translocation mediated by SlSWEET5b is required for pollen maturation in Solanum lycopersicum. Plant Physiol. 2022, 189, 344–359. [Google Scholar] [CrossRef]
- Wang, P.; Wei, P.; Niu, F.; Liu, X.; Zhang, H.; Lyu, M.; Yuan, Y.; Wu, B. Cloning and Functional Assessments of Floral-Expressed SWEET Transporter Genes from Jasminum sambac. Int. J. Mol. Sci. 2019, 20, 4001. [Google Scholar] [CrossRef] [PubMed]
- Seo, P.J.; Park, J.-M.; Kang, S.K.; Kim, S.-G.; Park, C.-M. An Arabidopsis senescence-associated protein SAG29 regulates cell viability under high salinity. Planta 2011, 233, 189–200. [Google Scholar] [CrossRef]
- Zhou, Y.; Liu, L.; Huang, W.; Yuan, M.; Zhou, F.; Li, X.; Lin, Y. Overexpression of OsSWEET5 in Rice Causes Growth Retardation and Precocious Senescence. PLoS ONE 2014, 9, e94210. [Google Scholar] [CrossRef]
- Ni, J.; Li, J.; Zhu, R.; Zhang, M.; Qi, K.; Zhang, S.; Wu, J. Overexpression of sugar transporter gene PbSWEET4 of pear causes sugar reduce and early senescence in leaves. Gene 2020, 743, 144582. [Google Scholar] [CrossRef]
- Yang, J.; Luo, D.; Yang, B.; Frommer, W.B.; Eom, J.-S. SWEET 11 and 15 as key players in seed filling in rice. New Phytol. 2018, 218, 604–615. [Google Scholar] [CrossRef]
- Zhang, X.; Feng, C.; Wang, M.; Li, T.; Liu, X.; Jiang, J. Plasma membrane-localized SlSWEET7a and SlSWEET14 regulate sugar transport and storage in tomato fruits. Hortic. Res. 2021, 8, 186. [Google Scholar] [CrossRef] [PubMed]
- Du, Y.; Li, W.; Geng, J.; Li, S.; Zhang, W.; Liu, X.; Hu, M.; Zhang, Z.; Fan, Y.; Yuan, X.; et al. Genome-wide identification of the SWEET gene family in Phaseolus vulgaris L. and their patterns of expression under abiotic stress. J. Plant Interact. 2022, 17, 390–403. [Google Scholar] [CrossRef]
- Gautam, T.; Dutta, M.; Jaiswal, V.; Zinta, G.; Gahlaut, V.; Kumar, S. Emerging Roles of SWEET Sugar Transporters in Plant Development and Abiotic Stress Responses. Cells 2022, 11, 1303. [Google Scholar] [CrossRef]
- Huang, D.-M.; Chen, Y.; Liu, X.; Ni, D.-A.; Bai, L.; Qin, Q.-P. Genome-wide identification and expression analysis of the SWEET gene family in daylily (Hemerocallis fulva) and functional analysis of HfSWEET17 in response to cold stress. BMC Plant Biol. 2022, 22, 211. [Google Scholar] [CrossRef]
- Mathan, J.; Singh, A.; Ranjan, A. Sucrose transport in response to drought and salt stress involves ABA-mediated induction of OsSWEET13 and OsSWEET15 in rice. Physiol. Plant. 2021, 171, 620–637. [Google Scholar] [CrossRef] [PubMed]
- Roy, S.; Sen, A.; Das, B.; Das, N.; Maiti, M.K.; Bhattacharya, S. Genome-wide in silico analysis indicates the involvement of OsSWEET transporters in abiotic and heavy metal (loid) stress responses in rice. Biologia 2022, 77, 1737–1755. [Google Scholar] [CrossRef]
- Valifard, M.; Le Hir, R.; Müller, J.; Scheuring, D.; Neuhaus, H.E.; Pommerrenig, B. Vacuolar fructose transporter SWEET17 is critical for root development and drought tolerance. Plant Physiol. 2021, 187, 2716–2730. [Google Scholar] [CrossRef]
- Yao, L.; Ding, C.; Hao, X.; Zeng, J.; Yang, Y.; Wang, X.; Wang, L. CsSWEET1a and CsSWEET17 Mediate Growth and Freezing Tolerance by Promoting Sugar Transport across the Plasma Membrane. Plant Cell Physiol. 2020, 61, 1669–1682. [Google Scholar] [CrossRef]
- Breia, R.; Conde, A.; Pimentel, D.; Conde, C.; Fortes, A.M.; Granell, A.; Gerós, H. VvSWEET7 Is a Mono- and Disaccharide Transporter Up-Regulated in Response to Botrytis cinerea Infection in Grape Berries. Front. Plant Sci. 2020, 10, 1753. [Google Scholar] [CrossRef]
- Gai, X.T.; Jiang, N.; Ma, J.; Wang, A.; Lu, C.; Xuan, Y.H.; Xia, Z.-Y. NtSWEET1 promotes tobacco resistance to Fusarium oxysporum-induced root rot disease. Plant Signal. Behav. 2021, 16, 1970940. [Google Scholar] [CrossRef]
- Gupta, P.K. SWEET Genes for Disease Resistance in Plants. Trends Genet. 2020, 36, 901–904. [Google Scholar] [CrossRef]
- Sun, M.; Zhang, Z.; Ren, Z.; Wang, X.; Sun, W.; Feng, H.; Zhao, J.; Zhang, F.; Li, W.; Ma, X.; et al. The GhSWEET42 Glucose Transporter Participates in Verticillium dahliae Infection in Cotton. Front. Plant Sci. 2021, 12, 690754. [Google Scholar] [CrossRef]
- Wu, L.; Eom, J.; Isoda, R.; Li, C.; Char, S.N.; Luo, D.; Schepler-Luu, V.; Nakamura, M.; Yang, B.; Frommer, W.B. OsSWEET11b, a potential sixth leaf blight susceptibility gene involved in sugar transport-dependent male fertility. New Phytol. 2022, 234, 975–989. [Google Scholar] [CrossRef]
- Behera, S.; Chauhan, V.B.S.; Pati, K.; Bansode, V.; Nedunchezhiyan, M.; Verma, A.K.; Monalisa, K.; Naik, P.K.; Naik, S.K. Biology and biotechnological aspect of sweet potato (Ipomoea batatas L.): A commercially important tuber crop. Planta 2022, 256, 40. [Google Scholar] [CrossRef] [PubMed]
- Yan, M.; Nie, H.; Wang, Y.; Wang, X.; Jarret, R.; Zhao, J.; Wang, H.; Yang, J. Exploring and exploiting genetics and genomics for sweetpotato improvement: Status and perspectives. Plant Commun. 2022, 3, 100332. [Google Scholar] [CrossRef]
- Dai, Z.; Yan, P.; He, S.; Jia, L.; Wang, Y.; Liu, Q.; Zhai, H.; Zhao, N.; Gao, S.; Zhang, H. Genome-Wide Identification and Expression Analysis of SWEET Family Genes in Sweet Potato and Its Two Diploid Relatives. Int. J. Mol. Sci. 2022, 23, 15848. [Google Scholar] [CrossRef]
- Li, Y.; Wang, Y.; Zhang, H.; Zhang, Q.; Zhai, H.; Liu, Q.; He, S. The Plasma Membrane-Localized Sucrose Transporter IbSWEET10 Contributes to the Resistance of Sweet Potato to Fusarium oxysporum. Front. Plant Sci. 2017, 8, 197. [Google Scholar] [CrossRef]
- Wu, X.L.; Wu, Z.D.; Wan, C.F.; Du, Y.; Gao, Y.; Li, Z.X.; Wang, Z.Q.; Tang, D.; Wang, J.C.; Zhang, K. Functional identification of sucrose transporter protein IbSWEET15 in sweet potato. Acta Agron. Sin. 2023, 49, 129–139. [Google Scholar]
- Chen, H.-Y.; Huh, J.-H.; Yu, Y.-C.; Ho, L.-H.; Chen, L.-Q.; Tholl, D.; Frommer, W.B.; Guo, W.-J. The Arabidopsis vacuolar sugar transporter SWEET2 limits carbon sequestration from roots and restricts Pythium infection. Plant J. 2015, 83, 1046–1058. [Google Scholar] [CrossRef] [PubMed]
- Reinders, A.; Sivitz, A.B.; Ward, J.M. Evolution of plant sucrose uptake transporters. Front. Plant Sci. 2012, 3, 22. [Google Scholar] [CrossRef] [PubMed]
- Reinders, A.; Sivitz, A.B.; Starker, C.G.; Gantt, J.S.; Ward, J.M. Functional analysis of LjSUT4, a vacuolar sucrose transporter from Lotus japonicus. Plant Mol. Biol. 2008, 68, 289–299. [Google Scholar] [CrossRef]
- Yuan, M.; Wang, S. Rice MtN3/Saliva/SWEET Family Genes and Their Homologs in Cellular Organisms. Mol. Plant 2013, 6, 665–674. [Google Scholar] [CrossRef] [PubMed]
- Feng, C.-Y.; Han, J.-X.; Han, X.-X.; Jiang, J. Genome-wide identification, phylogeny, and expression analysis of the SWEET gene family in tomato. Gene 2015, 573, 261–272. [Google Scholar] [CrossRef]
- Filyushin, M.A.; Anisimova, O.K.; Shchennikova, A.V.; Kochieva, E.Z. Genome-Wide Identification, Expression, and Response to Fusarium Infection of the SWEET Gene Family in Garlic (Allium sativum L.). Int. J. Mol. Sci. 2023, 24, 7533. [Google Scholar] [CrossRef] [PubMed]
- Liu, N.; Wei, Z.; Min, X.; Yang, L.; Zhang, Y.; Li, J.; Yang, Y. Genome-Wide Identification and Expression Analysis of the SWEET Gene Family in Annual Alfalfa (Medicago polymorpha). Plants 2023, 12, 1948. [Google Scholar] [CrossRef]
- Yue, W.; Cai, K.; Xia, X.; Liu, L.; Wang, J. Genome-wide identification, expression pattern and genetic variation analysis of SWEET gene family in barley reveal the artificial selection of HvSWEET1a during domestication and improvement. Front. Plant Sci. 2023, 14, 1137434. [Google Scholar] [CrossRef] [PubMed]
- Wieczorke, R.; Krampe, S.; Weierstall, T.; Freidel, K.; Hollenberg, C.P.; Boles, E. Concurrent knock-out of at least 20 transporter genes is required to block uptake of hexoses in Saccharomyces cerevisiae. FEBS Lett. 1999, 464, 123–128. [Google Scholar] [CrossRef] [PubMed]
- Chen, L. SWEET sugar transporters for phloem transport and pathogen nutrition. New Phytol. 2014, 201, 1150–1155. [Google Scholar] [CrossRef]
- Fatima, U.; Anjali, A.; Senthil-Kumar, M. AtSWEET11 and AtSWEET12: The twin traders of sucrose. Trends Plant Sci. 2022, 27, 958–960. [Google Scholar] [CrossRef]
- Guo, W.-J.; Nagy, R.; Chen, H.-Y.; Pfrunder, S.; Yu, Y.-C.; Santelia, D.; Frommer, W.B.; Martinoia, E. SWEET17, a Facilitative Transporter, Mediates Fructose Transport across the Tonoplast of Arabidopsis Roots and Leaves. Plant Physiol. 2014, 164, 777–789. [Google Scholar] [CrossRef]
- Klemens, P.A.W.; Patzke, K.; Deitmer, J.; Spinner, L.; Le Hir, R.; Bellini, C.; Bedu, M.; Chardon, F.; Krapp, A.; Neuhaus, H.E. Overexpression of the Vacuolar Sugar Carrier AtSWEET16 Modifies Germination, Growth, and Stress Tolerance in Arabidopsis. Plant Physiol. 2013, 163, 1338–1352. [Google Scholar] [CrossRef]
- Ruan, Y.-L. Sucrose Metabolism: Gateway to Diverse Carbon Use and Sugar Signaling. Annu. Rev. Plant Biol. 2014, 65, 33–67. [Google Scholar] [CrossRef] [PubMed]
- Liu, M.; Liu, T.; Lu, J.; Zhou, Y.; Liu, S.; Jiao, P.; Liu, S.; Qu, J.; Guan, S.; Ma, Y. Characterization and Functional Analysis of ZmSWEET15a in Maize. DNA Cell Biol. 2022, 41, 564–574. [Google Scholar] [CrossRef]
- Radchuk, V.; Belew, Z.M.; Gündel, A.; Mayer, S.; Hilo, A.; Hensel, G.; Sharma, R.; Neumann, K.; Ortleb, S.; Wagner, S.; et al. SWEET11b transports both sugar and cytokinin in developing barley grains. Plant Cell 2023, 35, 2186–2207. [Google Scholar] [CrossRef]
- Ren, Y.; Li, M.; Guo, S.; Sun, H.; Zhao, J.; Zhang, J.; Liu, G.; He, H.; Tian, S.; Yu, Y.; et al. Evolutionary gain of oligosaccharide hydrolysis and sugar transport enhanced carbohydrate partitioning in sweet watermelon fruits. Plant Cell 2021, 33, 1554–1573. [Google Scholar] [CrossRef] [PubMed]
- Hu, X.; Li, S.; Lin, X.; Fang, H.; Shi, Y.; Grierson, D.; Chen, K. Transcription Factor CitERF16 Is Involved in Citrus Fruit Sucrose Accumulation by Activating CitSWEET11d. Front. Plant Sci. 2021, 12, 809619. [Google Scholar] [CrossRef]
- Morkunas, I.; Ratajczak, L. The role of sugar signaling in plant defense responses against fungal pathogens. Acta Physiol. Plant. 2014, 36, 1607–1619. [Google Scholar] [CrossRef]
- Lukaszuk, E.; Rys, M.; Możdżeń, K.; Stawoska, I.; Skoczowski, A.; Ciereszko, I. Photosynthesis and sucrose metabolism in leaves of Arabidopsis thaliana aos, ein4 and rcd1 mutants as affected by wounding. Acta Physiol. Plant. 2016, 39, 17. [Google Scholar] [CrossRef]
- Durand, M.; Porcheron, B.; Hennion, N.; Maurousset, L.; Lemoine, R.; Pourtau, N. Water Deficit Enhances C Export to the Roots in Arabidopsis thaliana Plants with Contribution of Sucrose Transporters in Both Shoot and Roots. Plant Physiol. 2016, 170, 1460–1479. [Google Scholar] [CrossRef]
- Wu, Y.; Wu, P.; Xu, S.; Chen, Y.; Li, M.; Wu, G.; Jiang, H. Genome-Wide Identification, Expression Patterns and Sugar Transport of the Physic Nut SWEET Gene Family and a Functional Analysis of JcSWEET16 in Arabidopsis. Int. J. Mol. Sci. 2022, 23, 5391. [Google Scholar] [CrossRef]
- Wang, L.; Yao, L.; Hao, X.; Li, N.; Qian, W.; Yue, C.; Ding, C.; Zeng, J.; Yang, Y.; Wang, X. Tea plant SWEET transporters: Expression profiling, sugar transport, and the involvement of CsSWEET16 in modifying cold tolerance in Arabidopsis. Plant Mol. Biol. 2018, 96, 577–592. [Google Scholar] [CrossRef]
- Yang, G.; Xu, H.; Zou, Q.; Zhang, J.; Jiang, S.; Fang, H.; Wang, Y.; Su, M.; Wang, N.; Chen, X. The vacuolar membrane sucrose transporter MdSWEET16 plays essential roles in the cold tolerance of apple. Plant Cell Tissue Organ Cult. 2020, 140, 129–142. [Google Scholar] [CrossRef]
- Liu, X.; Zhang, Y.; Yang, C.; Tian, Z.; Li, J. AtSWEET4, a hexose facilitator, mediates sugar transport to axial sinks and affects plant development. Sci. Rep. 2016, 6, 24563. [Google Scholar] [CrossRef] [PubMed]
- Wu, Y.; Wang, S.; Du, W.; Ding, Y.; Li, W.; Chen, Y.; Zheng, Z.; Wang, Y. Sugar transporter ZmSWEET1b is responsible for assimilate allocation and salt stress response in maize. Funct. Integr. Genom. 2023, 23, 137. [Google Scholar] [CrossRef] [PubMed]
- Zhou, A.; Ma, H.; Feng, S.; Gong, S.; Wang, J. A Novel Sugar Transporter from Dianthus spiculifolius, DsSWEET12, Affects Sugar Metabolism and Confers Osmotic and Oxidative Stress Tolerance in Arabidopsis. Int. J. Mol. Sci. 2018, 19, 497. [Google Scholar] [CrossRef] [PubMed]
- Zhou, A.; Ma, H.; Feng, S.; Gong, S.; Wang, J. DsSWEET17, a Tonoplast-Localized Sugar Transporter from Dianthus spiculifolius, Affects Sugar Metabolism and Confers Multiple Stress Tolerance in Arabidopsis. Int. J. Mol. Sci. 2018, 19, 1564. [Google Scholar] [CrossRef]
- Gasteiger, E.; Hoogland, C.; Gattiker, A.; Duvaud, S.; Wilkins, M.R.; Appel, R.D.; Bairoch, A. Protein Identification and Analysis Tools on the ExPASy Server. In The Proteomics Protocols Handbook; Walker, J.M., Ed.; Humana Press: Totowa, NJ, USA, 2005; pp. 571–607. [Google Scholar]
- Waterhouse, A.; Bertoni, M.; Bienert, S.; Studer, G.; Tauriello, G.; Gumienny, R.; Heer, F.T.; De Beer, T.A.P.; Rempfer, C.; Bordoli, L.; et al. SWISS-MODEL: Homology modelling of protein structures and complexes. Nucleic Acids Res. 2018, 46, W296–W303. [Google Scholar] [CrossRef]
- Kumar, S.; Stecher, G.; Li, M.; Knyaz, C.; Tamura, K. MEGA X: Molecular Evolutionary Genetics Analysis across Computing Platforms. Mol. Biol. Evol. 2018, 35, 1547–1549. [Google Scholar] [CrossRef]
- Szklarczyk, D.; Kirsch, R.; Koutrouli, M.; Nastou, K.; Mehryary, F.; Hachilif, R.; Gable, A.L.; Fang, T.; Doncheva, N.T.; Pyysalo, S.; et al. The STRING database in 2023: Protein–protein association networks and functional enrichment analyses for any sequenced genome of interest. Nucleic Acids Res. 2023, 51, D638–D646. [Google Scholar] [CrossRef]
- Kohl, M.; Wiese, S.; Warscheid, B. Cytoscape: Software for visualization and analysis of biological networks. Methods Mol. Biol. 2011, 696, 291–303. [Google Scholar] [CrossRef]
- Gao, S.; Kong, Y.; Lv, Y.; Cao, B.; Chen, Z.; Xu, K. Effect of different LED light quality combination on the content of vitamin C, soluble sugar, organic acids, amino acids, antioxidant capacity and mineral elements in green onion (Allium fistulosum L.). Food Res. Int. 2022, 156, 111329. [Google Scholar] [CrossRef] [PubMed]
Disclaimer/Publisher’s Note: The statements, opinions and data contained in all publications are solely those of the individual author(s) and contributor(s) and not of MDPI and/or the editor(s). MDPI and/or the editor(s) disclaim responsibility for any injury to people or property resulting from any ideas, methods, instructions or products referred to in the content. |
© 2023 by the authors. Licensee MDPI, Basel, Switzerland. This article is an open access article distributed under the terms and conditions of the Creative Commons Attribution (CC BY) license (https://creativecommons.org/licenses/by/4.0/).